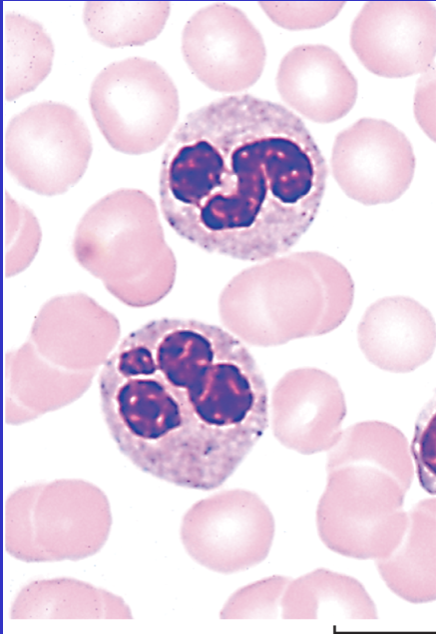
term image
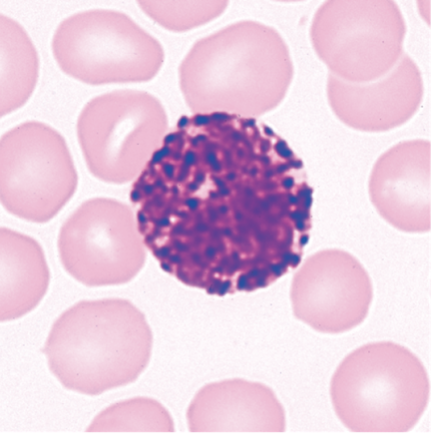
term image

heart and white blood cells
1/42
There's no tags or description
Looks like no tags are added yet.
Name | Mastery | Learn | Test | Matching | Spaced |
|---|
No study sessions yet.
43 Terms

right atrium

left atrium

Right ventricle

left ventricle

aortic arch

aortic semilunar valve

apex of heart

brachiocephalic artery

Chordae tendinae

inferior vena cava

interventricular septum

left atrioventricular valve (av valve)

left common carotid artery

left pulmonary artery

left subclavian artery

myocardium

papillary muscles

pulmonary trunk

pulmonary semilunar valve

pulmonary veins

right atrioventricular valve

right pulmonary artery

superior vena cava
neutrophils

Eosinophils
basophils

monocytes

lymphocytes
What is the full path of blood through the heart?
1.vena cava
2. Right atrium →
3. Tricuspid valve →
4. Right ventricle →
5. Pulmonary valve →
6. Pulmonary artery →
7. Lungs →
8. Pulmonary veins →
9. Left atrium →
10. Mitral valve →
11. Left ventricle →
12. Aortic valve →
13. Aorta →
14. Body
1st step in blood flow enters
vena cava
2nd step in blood flow
right atrium
3rd step in blood flow
right av valve
4th step in blood flow
right ventricle
5th step in blood flow
pulmonary valve
6th step in blood flow
Pulmonary artery
7th step in blood flow
Lungs
8th step in blood flow
Pulmonary veins
9th step in blood flow
Left atrium
10th step in blood flow
left av valve
11th step in blood flow
Left ventricle
12th step in blood flow
Aortic valve
13th step in blood flow
aorta
last step in blood flow
body